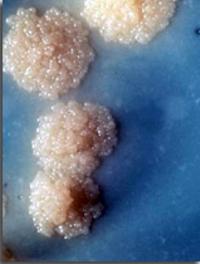

La décontamination systématique des résidents en EHPAD réduit les risques d'hospitalisation
On estime que 1,6 à 3,8 millions d’infections nosocomiales surviennent chaque année dans les maisons de retraite aux États-Unis, entraînant [...]

L’essai CODA est la plus vaste étude ayant comparé, en cas d’appendicite confirmée par imagerie, antibiothérapie vs chirurgie. Il a [...]

Il semble admis que les symptômes observés pendant la phase précoce de la COVID-19 reflètent la phase de réplication virale et que [...]

A la date du mois de Janvier 2022, plus de 5,4 millions d’individus à travers le monde étaient morts de la Covid-19, le plus souvent [...]

Près de 3 femmes sur 4 font l’expérience au cours de leur vie d’une mycose vaginale. La moitié d’entre elles présentent une récurrence [...]

Les anticorps monoclonaux occupent une place importante dans le traitement de la Covid-19. Certains d’entre eux réduisent le risque [...]

REGEN-COV, initialement connu sous le nom de REGN-COV2, est la combinaison de deux anticorps monoclonaux neutralisants, respectivement [...]

Les formes graves de la Covid-19 se caractérisent par une réponse immunitaire exacerbée qui se manifeste par un véritable orage cytokinique [...]

Le remdésivir conçu initialement pour traiter l’infection à virus Ebola est un médicament qui, in vitro, est à même d’inhiber l’ARN [...]

Les infections précoces à Virus Respiratoire Syncytial (VRS) exposent à des formes sévères de bronchiolites durant les six premiers [...]

Le remdesivir est un antiviral développé initialement pour traiter l’infection par le virus Ebola, mais il fait preuve in vitro comme [...]

Le ténofovir alafénamide (TAF ou Vemlidy®) et le ténofovir disoproxil fumarate (TDF ou Viread®) présentent une efficacité similaire [...]

Selon l’OMS, la tuberculose conserve une position dominante parmi les causes de mortalité, tout au moins dans la liste des maladies [...]

La phase 1 de l’étude PARTNER, menée sur 75 sites dans 14 pays européens, a montré que le risque de transmission du VIH était nul dans [...]

Certaines régions endémiques pour le paludisme sont également infestées par la filariose et la population y bénéficie régulièrement [...]

Chaque année, des dispositifs électroniques cardiaques implantables (DECI) sont implantés chez environ 1,5 millions de patients à l’échelon [...]

Le principal obstacle au traitement de la tuberculose est la mauvaise observance. Celle-ci est favorisée par la nécessité de la prise [...]

Dans un contexte d’augmentation des résistances bactériennes et de la nécessité de nouveaux agents actifs, le New England Journal of [...]

La prise en charge thérapeutique des infections orthopédiques complexes repose en règle sur l’administration parentérale prolongée [...]

Chaque année, 1,7 millions de consultations aux urgences aux USA sont liées à des gastroentérites. Par ailleurs, les probiotiques ont [...]

L’Organisation Mondiale de la Santé a ciblé l’objectif de l’élimination de la filariose lymphatique d’ici 2020 grâce aux stratégies [...]
L'équation Undetectable = Untransmittable se vérifie aujourd'hui avec les résultats de l'étude PARTNER 2 dont les premières données [...]

Le traitement de l’endocardite infectieuse du cœur gauche repose sur une antibiothérapie parentérale prolongée dont la durée peut atteindre [...]

A l’âge de 5 ans, 5 à 8 enfants sur 10 présenteraient une otite séreuse. Les antibiotiques, décongestionnants ou corticoïdes par voie [...]

L’assistance respiratoire des bronchiolites aiguës peut faire appel à l’oxygénothérapie standard [O2 standard], à l’oxygénothérapie [...]

Depuis le premier essai en double aveugle d’administration d’hydrocortisone (HC) dans la prise en charge du choc septique en 1963, [...]

Les infections sur site opératoire (ISO) représentent plus de 20 % des infections nosocomiales et c’est la chirurgie colorectale (CCR) [...]

L’observance thérapeutique reste un problème majeur dans le suivi des patients atteints par le VIH. Une faible compliance est à l’origine [...]

Les infections à Clostridium difficile sont la première cause de diarrhées chez les patients hospitalisés dans les pays développés. [...]

En dépit de nouveaux traitements plus efficaces et plus sûrs, les candidoses invasives et les candidémies restent entachées d’une forte [...]

Les bactériémies sur cathéter sont fréquentes et associées à un taux élevé de mortalité. Le point d’insertion cutané et les raccords [...]

Le dépistage du VIH et l’utilisation de préservatifs sont au cœur des stratégies pour réduire le risque de transmission du virus. L’efficacité [...]

L’aspergillose invasive (IA) complique fréquemment les hémopathies malignes (HM) et les greffes de cellules hématopoïétiques (HCT). [...]

Le traitement des infections intra-abdominales repose schématiquement sur un contrôle correct du foyer infectieux (par drainage percutané [...]

Les effets extra-osseux de la vitamine D sont l'objet d'une très abondante littérature qui concerne en particulier son action immuno-modulatrice. [...]

Les infections hospitalières entraînent une prolongation de la durée d’hospitalisation mais aussi une augmentation de la mortalité [...]

Les accidents vasculaires cérébraux (AVC) se compliquent fréquemment d'infections, les plus fréquentes étant des pneumonies et des [...]

Malgré un essai de phase 2 négatif, MR Capeding et coll. rapportent aujourd’hui l’efficacité d’un premier vaccin tétravalent (vivant [...]

La tuberculose reste à ce jour un problème préoccupant, à cause de l’apparition de souches multi-résistantes aux traitements conventionnels [...]

Les femmes enceintes, à partir du 2ème trimestre de la grossesse et jusqu'au post-partum immédiat, sont à risque de grippe grave. Il [...]

La méricitabine est un inhibiteur nucléosidique de l’ARN polymérase dépendante de l'ARN NS5B du virus de l'hépatite C (VHC). Elle possède [...]

Le sofosbuvir est un analogue nucléotidique de l’uridine qui inhibe sélectivement la polymérase NS5B du virus de l’hépatite C (VHC).
Cette [...]

La prise en charge de l'hépatite C chronique connaît actuellement une évolution manifeste avec l'arrivée de nouvelles molécules.
Des [...]

En 1958, une équipe de Denver (Colorado), confrontée à des patients atteints de colites pseudo-membraneuses fulminantes a eu l’idée [...]

Du fait de l'émergence de résistances, en particulier à la clarithromycine, les modalités optimales de traitement d'éradication de [...]
Les effets de la suppression prolongée de la réplication du virus de l'hépatite B (VHB) sur la régression de la fibrose hépatique associée [...]

L’infection par Mycobacterium tuberculosis est responsable de près de 2 millions de décès annuels dans le monde. Avec un réservoir [...]
En 1998, un vaccin vivant atténué contre le rotavirus, le Rotashield, était autorisé et recommandé aux Etats-Unis pour la prévention [...]

Le lecteur assidu de la presse médicale internationale ressent parfois une certaine lassitude lorsqu’il prend connaissance des thèmes [...]

Certains travaux ont récemment suggéré que l’administration parentérale de glutamine aux patients en situation critique réduisait la [...]

Jusqu’à l’apparition des antibiotiques, l’otite moyenne aiguë (OMA) de l’enfant était considérée comme une affection grave et les traités [...]

Pour des raisons culturelles, la prévention du sida chez la femme, ne peut reposer, en Afrique plus encore qu’ailleurs, sur le seul [...]

Les Etats-Unis, de longue date, et l’Europe depuis quelques années, disposent d’agences du médicament (FDA et EMEA) qui sont chargées, [...]

Il y a tout juste 50 ans W B Kouwenhoven décrivait dans le JAMA, la technique du massage cardiaque externe (MCE). Peu après, les réanimateurs [...]
Les pneumopathies post-opératoires sont l’une des complications les plus fréquentes de la chirurgie. Leur incidence, entre 2 % et 20 [...]

L’otite moyenne aiguë (OMA) est la cause la plus fréquente de prescriptions d’antibiotiques (AB) en pédiatrie. Le taux d’utilisation [...]

Il y a 18 mois dans le Lancet, des experts travaillant pour l’OMS, proposaient de changer radicalement de politique de traitement de [...]

Pediculus humanus capitis, qui n’est autre que le pou de tête, est un parasite qui infeste la chevelure de plus de 100 millions de [...]
La leishmaniose viscérale ou kala-azar (maladie noire en langue Assam) est une infection parasitaire qui sévit particulièrement en [...]

Cette nouvelle ne bouleversera sans doute pas les praticiens européens pour qui la probabilité d’être confronté à un ulcère de Buruli [...]

Les infections à Clostridium difficile ont la particularité d’être favorisées par les traitements antibiotiques à large spectre et [...]

Les rotavirus sont la première cause de gastro-entérites infantiles. Si, dans les régions développées ces infections très fréquentes [...]

La transmission materno-fœtale (TMF) du VIH est aujourd'hui la principale cause de contamination de l'enfant. Les différents facteurs [...]

La prescription prophylactique d’antipyrétique et tout particulièrement de paracétamol après une vaccination du nourrisson est une [...]

A l’âge de 7 ans, 2 % des garçons et 8 % des filles ont présenté une infection urinaire (IU). Ces épisodes sont favorisés par des reflux [...]
A partir du milieu des années 90, à une époque où les multithérapies anti-rétrovirales prenaient leur essor, plusieurs essais cliniques [...]

L’utilisation d’oxygénateurs extracorporels à membrane, communément appelés ECMO (pour ExtraCorporeal Membrane Oxygenation) se développe [...]

Dès les premières années qui ont suivi l’apparition du sida de nombreux travaux épidémiologiques ont montré que les hommes circoncis [...]
Alors qu’elle avait quasiment disparu au début des années 60, la maladie du sommeil (ou trypanosomiase africaine) demeure, en 2009, [...]
Les chiffres et faits de la tuberculose demeurent très préoccupants, malgré cette soi- disant baisse de l’incidence mondiale de l’infection [...]

Le groupe Européen de travail sur Helicobacter pylori (H pylori) a récemment publié ses recommandations pour la prise en charge de [...]
La prévention du sida repose toujours essentiellement sur le préservatif masculin. Mais sur le terrain, en particulier en Afrique, [...]

Le moment optimum pour débuter un traitement anti-rétroviral a été l’objet de débats passionnés depuis l’apparition de la zidovudine [...]

Les recherches sur un vaccin préventif contre le sida sont moins médiatisées depuis l’avènement des multithérapies anti-rétrovirales, [...]

Le traitement de l’infection à HIV repose actuellement sur l’association de plusieurs anti-rétroviraux agissant à différentes étapes [...]

Les études ORACLE I et II publiées dans le Lancet en 2001 sont de celles qui ont marqué la périnatalogie. ORACLE I a démontré qu’en [...]

Un essai contrôlé et randomisé, en double insu, démontre l’absence d’effets indésirables à 2 ans d’un symbiotique (probiotique + prébiotique) [...]

Il y a des introductions qui ouvrent l’appétit (médical et scientifique) et celle de SA. Frech en fait incontestablement partie ! Cette [...]
Le congrès de l’American Academy of Neurology est l’événement annuel du monde Neurologique. Il est le témoin de l’intense recherche [...]
Les néoplasies vulvaires intra-épithéliales (NVIE) sont des lésions liées à une infection à HPV qui peuvent évoluer vers le cancer [...]
Le choléra est une maladie infectieuse diarrhéique due à des souches appartenant aux sérogroupes 01 et 0139 du Vibrio cholerae. Il [...]
L’indication d’un traitement corticoïde dans le choc septique est un serpent de mer qui resurgit régulièrement. Après diverses études [...]

La sinusite aiguë est un problème fréquent dans la pratique médicale courante. Elle débouche souvent sur l’administration d’antibiotiques [...]

Après un contact potentiellement infectant avec le virus de l’hépatite A (VHA), qu’il s’agisse d’un contact direct avec un sujet malade [...]
L’incidence croissante des candidoses invasives chez les malades gravement atteints a conduit au développement de nombreuses molécules [...]

Les tableaux infectieux, et tout particulièrement les infections respiratoires aiguës, demeurent la première cause de mortalité chez [...]
La chirurgie colique, même en dehors de l’urgence, est à très haut risque infectieux. Parmi les diverses mesures préconisées pour réduire [...]
SFGG – Paris. Le zona et une maladie fréquente dont l’incidence augmente avec l’âge. On estime qu’après 75 ans l’incidence annuelle [...]
Peu après l’avènement des multithérapies anti-rétrovirales (HAART), il est apparu que, contrairement à ce que l’on aurait pu espérer, [...]
En 1906, JA Blake publiait dans une revue d’obstétrique des observations d’amélioration de tétanos grâce au sulfate de magnésium. La [...]

L’otite aiguë moyenne (OAM) est l’une des indications les plus fréquentes de l’antibiothérapie chez l’enfant. Chaque année, aux Etats-Unis, [...]

Bien que des dizaines de millions de nourrissons soient vaccinés chaque année dans le monde, la longueur et la largeur optimales de [...]